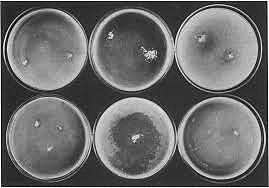
Lieske y Gratia

-
-
-
-
-
Causó intoxicaciones y fallecimientos
-
-
-
-
-
-
-
-
-
Comprobaron que la Penicilina era capaz de detener el crecimiento del estafilococo y disolvía el antrax.
-
Penso que podria cultivarse de forma aislada
-
Fármaco con acción bactericida
-
-
-
Primer medicamento específico contra la
tuberculosis, -
-
Por Rene Dubos
-
mientras trabajaba con un hongo del agua llamado Cephalosporium acreomonium ,
-
-
-
Causante de la muerte de los microbios
-
-
-
-
-
Fue aislado en los laboratorios de Lilly
-
Por el Dr. Benjamin Dugger
-
Want to make a timeline like this?
Use Timetoast to turn dates, events, milestones, and phases into a clear visual timeline you can build and share. Timetoast is a timeline maker for work, school, research, and stories.